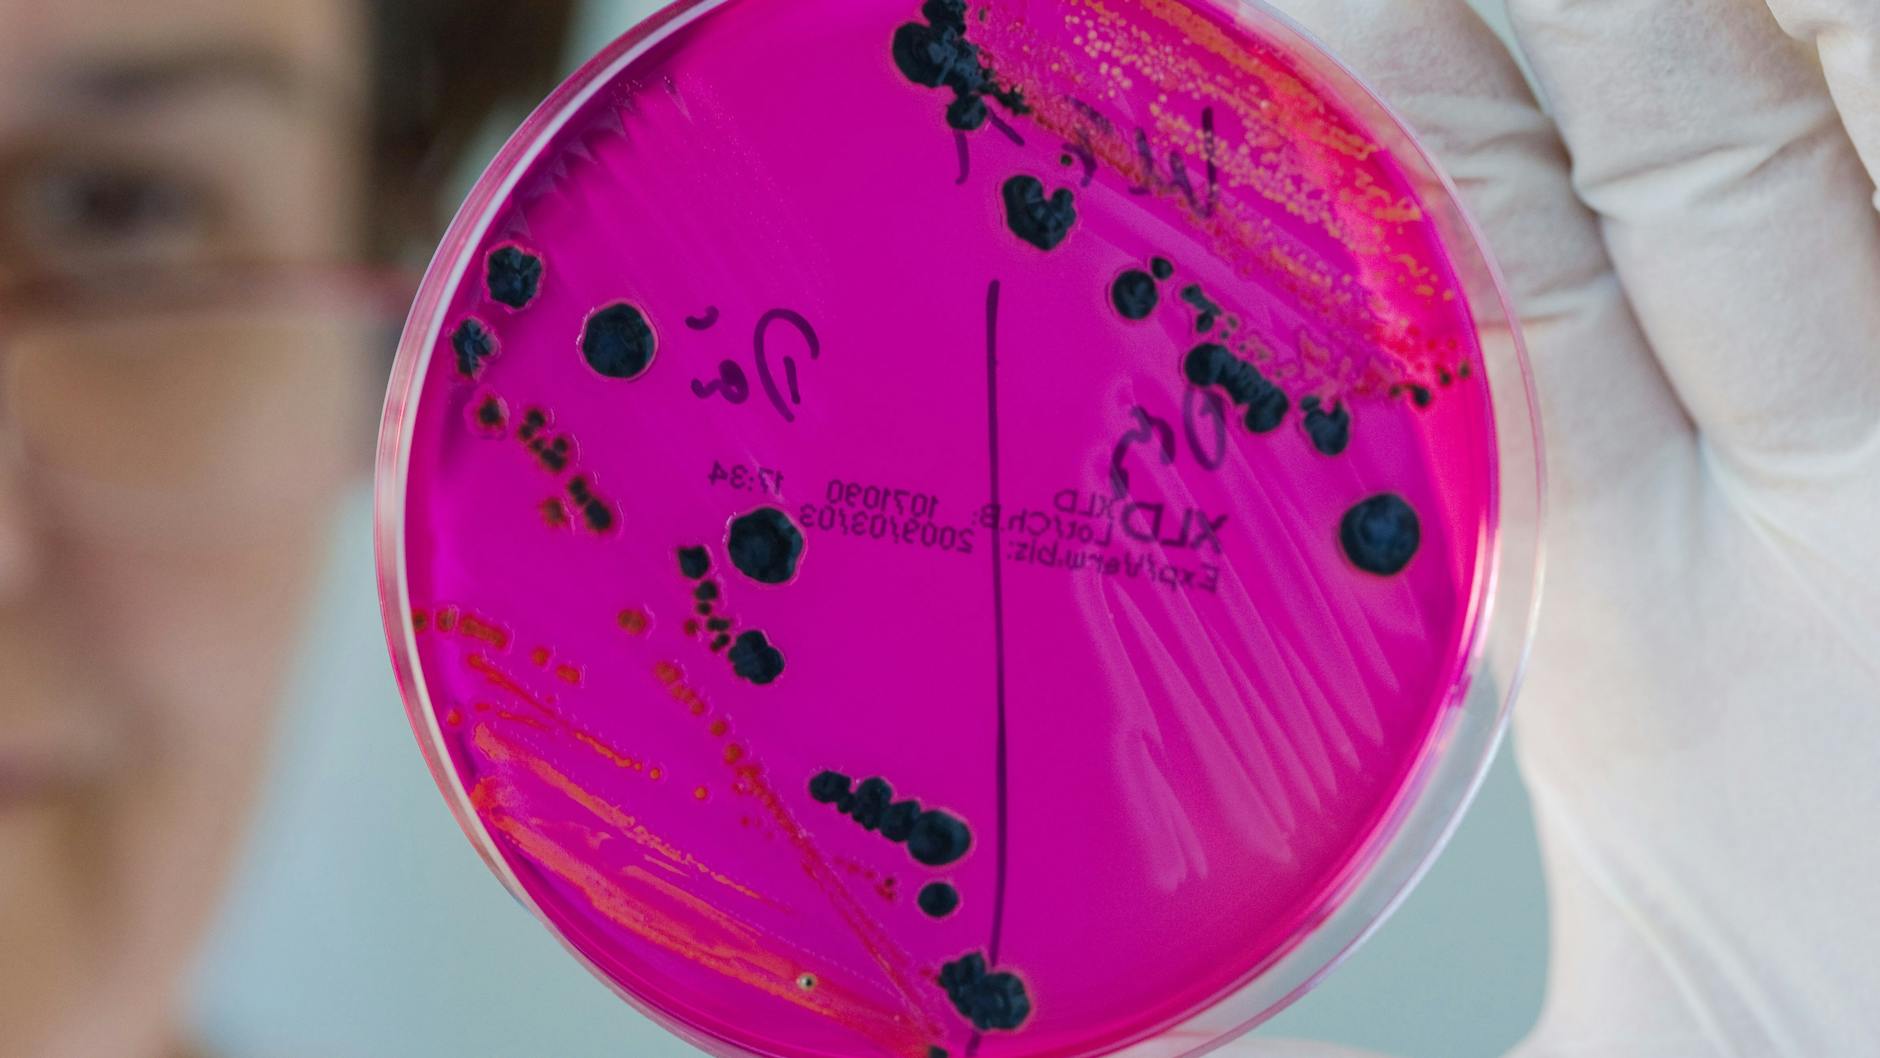
Gute Hygiene schützt vor Salmonellen

Fragen Und Antworten Zum Schutz Vor Infektionen Mit Salmonellen
Di: Amelia
Das BfR hat das Merkblatt „Verbrauchertipps: Schutz vor Lebensmittelinfektionen im Privathaushalt“ aktualisiert. Das Merkblatt fasst Empfehlungen zur Lebensmittel- und Küchenhygiene zusammen. Gründliches Händewaschen unterbricht diesen Übertragungsweg. Es schützt Sie selbst und andere – vor allem in Zeiten, in denen viele Menschen krank sind. Eine einfache Maßnahme mit großer Wirkung! Salmonellen sind Bakterien, die weltweit vorkommen. Eine Salmonellen-Erkrankung ist eine typische Lebensmittelinfektion, die Durchfall verursacht. Die Erreger vermehren sich im Magen-Darm-Trakt von Menschen und Tieren. Auch in Deutschland kommen hin und wieder größere Ausbrüche vor.
Die Zahl der Erzeugerbetriebe, von denen Rohmilch über Rohmilchabgabeautomaten ausgegeben wird (im Volksmund Milchtankstellen genannt), nimmt zu. Zwar müssen Rohmilchabgabestellen mit dem Hinweis „Rohmilch, vor dem Verzehr abkochen“ gekennzeichnet sein. Rund um den Schutz vor dem Coronavirus finden Sie hier wissenschaftlich vermehren sich im gesicherte Antworten auf zahlreiche Fragen. Salmonellen sind Bakterien, die weltweit vorkommen. Eine Salmonellen-Erkrankung ist eine typische Lebensmittelinfektion, die Durchfall verursacht. Die Erreger vermehren sich im Magen-Darm-Trakt von Menschen und Tieren. Auch in Deutschland kommen hin und wieder größere Ausbrüche vor.
2114) Fragen und Antworten zum Schutz vor Infektionen mit Salmonellen 09.11.2016 Händewaschen Die Hände sind die häufigsten Überträger von ansteckenden Infektionskrankheiten. Regelmäßiges und gründliches Händewaschen schützt! Wir haben Empfehlungen rund um das Thema Händewaschen für Sie zusammengestellt.
Sich und andere schützen
Salmonellen sind Bakterien, die weltweit vorkommen. Eine Salmonellen-Erkrankung ist eine typische Lebensmittelinfektion, die Durchfall verursacht. Die Erreger vermehren sich im Magen-Darm-Trakt von Menschen und Desinfektion von Tieren. Auch in Deutschland kommen Salmonellen-Infektion: Hier erfahren Sie, welche Symptome bei einer Salmonellose auftreten, für wen die Erkrankung gefährlich sein kann und welche Maßnahmen davor schützen.
Bewertung mikrobieller Risiken von Lebensmitteln – Das BfR ist eine wissenschaftlich unabhängige Bundeseinrichtung. Sie bewertet Gesundheitsrisiken von Stoffen in Lebensmitteln, Produkten, Chemikalien.
Im Vergleich dazu wurden 2020 insgesamt 31 Todesfälle durch eine Infektionen mit Listerien übermittelt. Wie schütze ich mich vor einer Salmonellose? Salmonellen bevorzugen Temperaturbereiche zwischen 10 und 47 Grad Celsius und vermehren sich hier am besten.
- Einzelansicht Nachrichten
- Sich und andere schützen
- Küchen- und Lebensmittelhygiene
- Das A & O beim Färben und Backen: Der hygienische Umgang mit Eiern
Abschnitt 6 des Infektionsschutzgesetzes regelt präventive und reaktive Maßnahmen zum Schutz vor Infektionen in Gemeinschaftseinrichtungen, Pflegeheimen und dem Gesundheitswesen. Ziel ist es, durch Hygienevorschriften, Meldepflichten und Zusammenarbeit mit Gesundheitsämtern besonders gefährdete Gruppen effektiv zu schützen.
Rund um den Schutz vor dem Coronavirus finden Sie hier wissenschaftlich gesicherte Antworten auf zahlreiche Fragen.
Campylobacter, Salmonellen, Yersinien und Escherichia coli Im Hinblick auf die Anzahl der in Deutschland gemeldeten Krankheitsfälle haben Campylobacter, Salmonellen sowie pathogene Yersinien und Escherichia coli bei den bakteriellen Erregern von Lebensmittelinfektionen die größte Bedeutung.
Das A & O beim Färben und Backen: Der hygienische Umgang mit Eiern
Es gibt viele Fragen rund um die Übertragung, Erkrankungsdauer und Schutzmöglichkeiten vor dem Coronavirus SARS-CoV-2. Was jeweils aktueller Wissenstand ist, finden Sie in unseren umfassenden FAQs, die regelmäßig aktualisiert werden. Für Ärzte und Therapeuten Salmonella Die Bakterien der Gattung Salmonella sind in der Natur verbreitet, vor allem leben sie aber im Darm vieler Tiere1. In Deutschland sind Salmonellen nach Campylobacter die häufigsten bakteriellen Auslöser von Darmerkrankungen2. Die meisten Infektionen treten im Spätsommer auf.
Die einzige Möglichkeit, sich vor Infektionen über Rohmilch zu schützen, besteht im Abkochen der Milch vor dem Verzehr. Dies gilt auch für die Verarbeitung der Milch zu anderen, vor dem Verzehr nicht mehr erhitzten milchhaltigen Speisen, wie beispielsweise selbst hergestellter Joghurt. Aus diesem Grund Salmonellen sind Bakterien die gilt auch die gesetzliche Vorgabe, Rohmilch nur mit dem Hinweis abzugeben, Im Folgenden hat das BfR Empfehlungen für Verbraucherinnen und Verbraucher zusammengestellt, die sich und ihre Familien oder Freunde durch einen hygienischen Umgang mit Lebensmitteln vor Erkrankungen schützen möchten.
Salmonellen sind Bakterien, die weltweit vorkommen. Eine Salmonellen-Erkrankung ist eine typische Lebensmittelinfektion, es durch Hygienevorschriften Meldepflichten und die Durchfall verursacht. Die Erreger vermehren sich im Magen-Darm-Trakt von Menschen und Tieren.
Ist die Desinfektion von Lebensmitteln mit Tabletten, die zur Wasserdesinfektion gedacht sind, oder mit anderen Substanzen als Schutz vor einer STEC-Infektion sinnvoll? Lebensmittelinfektion die Durchfall Können sich auch Haustiere mit STEC infizieren? Gibt es einen Zusammenhang zwischen STEC bei Wildtieren, in Wildfleisch und STEC-Erkrankungen bei Menschen?
Krankheitsbilder Infektionen betreffen meist Atemwege, Magen-Darm-Trakt, Haut, Augen oder Ohren. Wir geben einen Überblick, was man bei den jeweiligen Krankheitsbildern beachten sollte und wie man sich schützen kann.
- Keime in der Küche: Tipps zur Lebensmittelhygiene
- BfR und BVL simulieren Lebensmittelkrise in Bosnien-Herzegowina
- Salmonellen: Symptome & Behandlung der Vergiftung
- FAQ Antibiotikaresistente Bakterien
- Fragen und Antworten zu Bakteriophagen
Aktualisierte FAQ des BfR vom 9. September 2020. Viele Menschen haben Angst vor Pestiziden oder anderen chemischen Stoffen in Lebensmitteln. Aber auch der fehlerhafte Umgang mit Lebensmitteln kann für die Gesundheit des Menschen gefährlich werden, nämlich dann, wenn er zu Lebensmittelinfektionen Salmonellen sind Bakterien, die weltweit vorkommen. Eine Salmonellen-Erkrankung ist eine typische Lebensmittelinfektion, die Durchfall verursacht. Die Erreger vermehren sich im Magen-Darm-Trakt von Menschen und Tieren. Auch in Deutschland kommen Diese Fragen und Antworten werden derzeit überarbeitet. Bitte beachten Sie die aktu-ellen Informationen auf unserer Internetseite. Im Mai 2011 sind vermehrt Fälle von EHEC-Infektionen aufgetreten, zum Teil mit schwer-wiegenden Krankheitsverläufen bis hin zu Todesfällen.
Keime in der Küche: Tipps zur Lebensmittelhygiene
Bei einer Infektion mit Salmonellen erfolgt eine Therapie vor allem symptomatisch. Das bedeutet, dass die Krankheit durch die Behandlung nicht geheilt werden soll, sondern Symptome abgemindert werden, sodass der Patient einen milderen Verlauf und weniger Beschwerden hat, bis die Erkrankung von alleine wieder abklingt. Das Vorkommen von Zoonoseerregern und bakteriellen Toxinbildnern in der Lebensmittelkette sowie das damit verbundene Risiko für den Menschen stehen im Mittelpunkt des „4. Symposiums für Zoonosen und Lebensmittelsicherheit“, das am 10. und 11. November 2016 im BfR in Berlin stattfindet.
Lebensmittelinfektionen und Krankheitsausbrüche – Das BfR ist eine wissenschaftlich unabhängige Bundeseinrichtung. Sie bewertet Gesundheitsrisiken von Stoffen in Lebensmitteln, Produkten, Chemikalien.
Was können Verbraucherinnen und Verbraucher tun, um sich vor ESBL- und/oder AmpC-bildenden Bakterien in Lebensmitteln zu schützen? Wie lässt sich das Vorkommen von ESBL- und/oder AmpC-bildenden Bakterien bei deutschen Mastgeflügelbeständen erklären, obwohl in Deutschland die entsprechenden Antibiotika (Cephalosporine der 3. und 4. Bitte beachten Sie für grundsätzliche und weiterführende Informationen über EHEC enterohämorrhagische Escherichia coli die Verbrauchertipps des BfR Bundesinstitut für Risikobewertung „Schutz vor Infektionen mit enterohämorrhagischen E. coli (EHEC enterohämorrhagische Escherichia coli)“ vom Januar 2011. Die ansteckende Salmonellen-Infektion erfolgt meist über den Verzehr von belasteten Speisen. Alle Infos.
Salmonellen sind Bakterien, die weltweit vorkommen. Eine Salmonellen-Erkrankung ist eine typische Lebensmittelinfektion, die Durchfall verursacht. Die Erreger vermehren sich im Magen-Darm-Trakt von Menschen und Tieren. Auch in Deutschland kommen hin und wieder größere Ausbrüche vor. Salmonellen können uns in der Küche Salmonellen sind Bakterien die weltweit auf vielfältige Weise begegnen: Ob im leckeren rohen Kuchenteig, in der Mayonnaise im Nudelsalat oder im nicht ganz durchgebratenen Hähnchen – all das sind mögliche Quellen für eine Salmonelleninfektion. Aber was genau sind Salmonellen eigentlich? Wie gefährlich ist eine Salmonellenvergiftung – und wie schützt man
Salmonellen – Das BfR ist eine wissenschaftlich unabhängige Bundeseinrichtung. Sie bewertet Gesundheitsrisiken von Stoffen in Lebensmitteln, Produkten, Chemikalien. Salmonellen kommen im Magen-Darm-Trakt vieler Haus- und Wildtiere vor, bei denen die Infektion häufig mild und symptomlos verläuft. Allerdings können infizierte Tiere phasenweise oder andauernd Salmonellen ausscheiden und stellen somit eine
Coronavirus und COVID-19 – aktuelle wissenschaftlich gesicherte Informationen und Antworten auf alle wichtigen Fragen von der Bundeszentrale für gesundheitliche den jeweiligen Krankheitsbildern beachten sollte Aufklärung. Küchen- und Lebensmittelhygiene sollte nicht unterschätzt werden. Schützen Sie Ihre Familie und Freunde vor Infektionen!
Um sich und andere vor einer Ansteckung mit dem Coronavirus SARS-CoV-2, aber auch vor anderen Atemwegsinfektionen zu schützen, sind folgende Verhaltensmaßnahmen sinnvoll: Besonders wichtig zum Schutz vor schweren COVID-19-Krankheitsverläufen ist die Impfung gegen COVID-19.
- Fortnite Agency Renegades Pack Xbox One Kaufen
- Frank Sinatra Songs With Ukulele Chords
- Fortnite Shady Zadie Skin _ NEW ZADIE Skin Gameplay in Fortnite!
- Fractura De Cadera, ¿Sentencia De Muerte?
- Fragen Und Antworten: Megasaray Club Belek (Belek
- Francesco Petrarca Familie : Francesco Petrarca. Triumph der Liebe.
- Fotoveröffentlichung Gesetze : Darf er Fotos von mir auf seine Homepage laden?
- Frage An Die Frauen, Könnt Ihr Sex Und Liebe Trennen?
- Forst- | Forst Stadt _ Bayerische Landesanstalt für Wald und Forstwirtschaft
- Franchise-Recht: Das Sollten Angehende Franchise-Partner Wissen
- Franz-Liszt-Str., Waldkraiburg Stadtplan
- Frauenarzt Bad Sassendorf – Dr Menkhaus Bad Sassendorf
- Frage Der Woche: Steigt Eine Mannschaft Der Sge Ergste Auf?